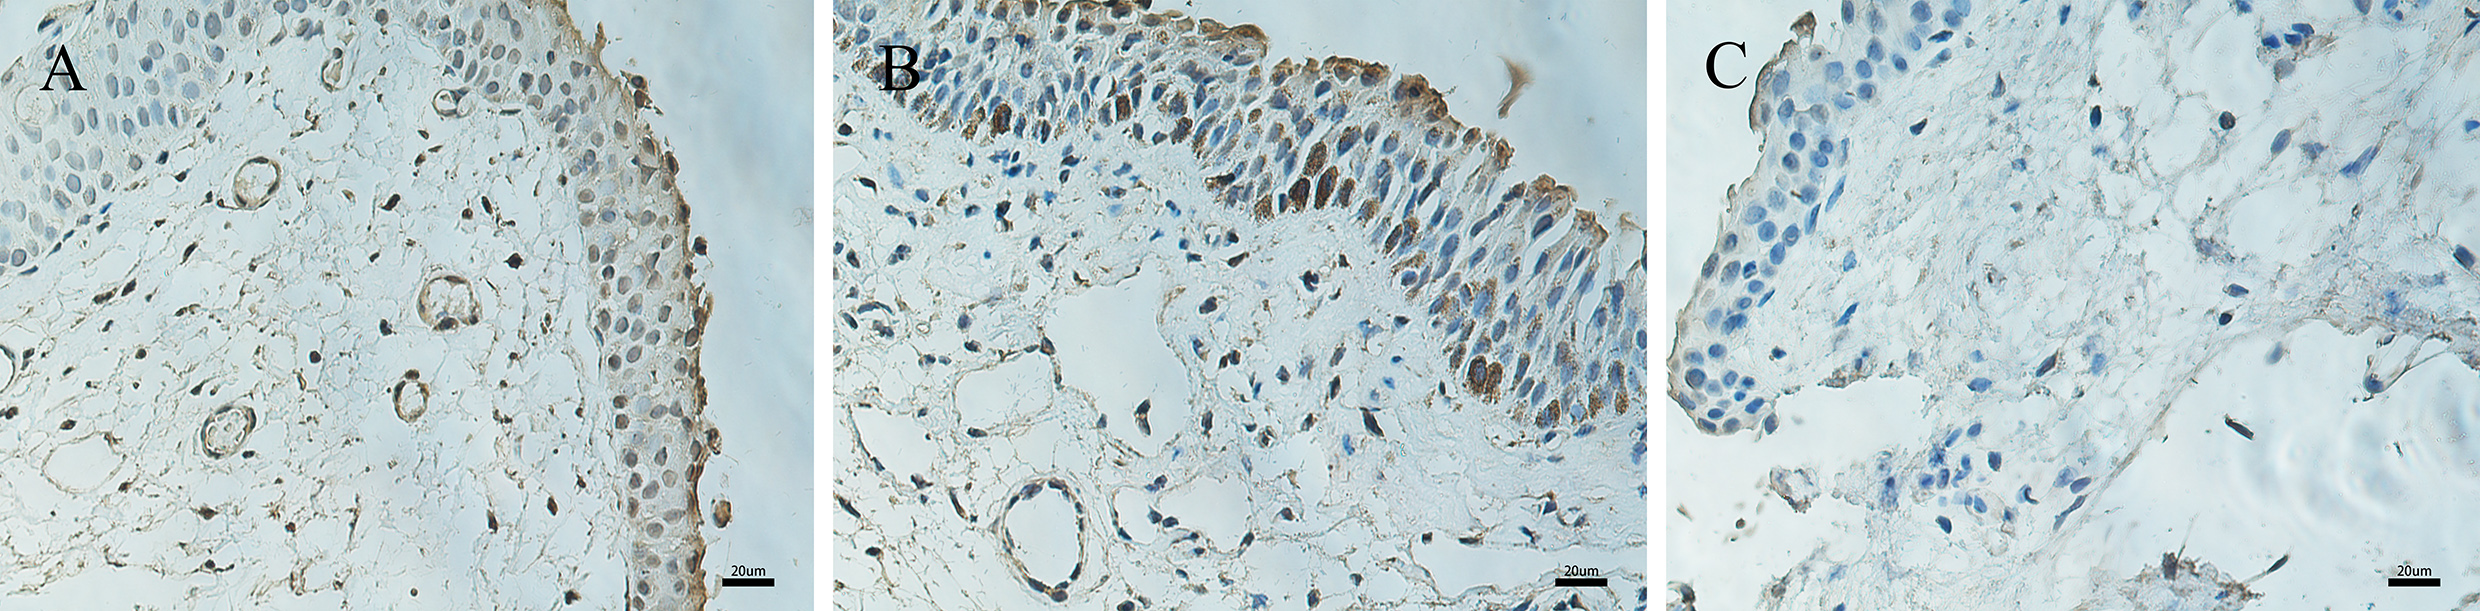

Figure 3. Immunohistochemical expression of VEGF in pterygium and normal conjunctiva. Immunohistochemical expression of VEGF in pterygium
(A–B) and normal conjunctiva (C). A: Epithelial and stromal layers display moderate VEGF immunoreactivity. B: There is moderate to strong nuclear immunoreactivity in the basal layers of epithelial cells. C: There is almost no positive expression in control conjunctival tissue (400X, bar = 20 μm).